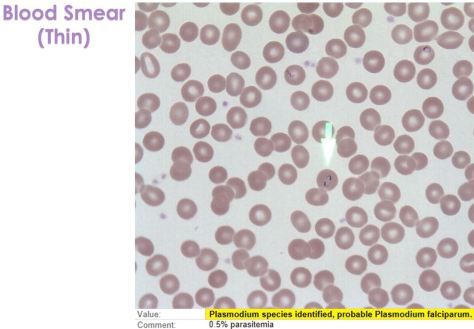
M6

There are 2 main stages –> Hepatic stage and RBC Stage
- 1) Infected Anopheles mosquito bites a human and transmits sporozoites into the bloodstream
- 2) Sporozoites (spore-like stage) travel to the liver and invade hepatocytes
- Then they divide to form hepatic schizonts (“schizo-“ meaning divided)
- The incubation period lasts about 2 weeks!
- 3) Hypnozoites (specific to P. vivax and ovale) can remain quiescent in the liver until reactivation, causing relapse after months
- 4) Schizonts rupture and release merozoites into the circulation which invade RBCs (RBC Schizont) and start this infection cycle
- OR 5) Merozoites can turn into gametocytes that are taken up and spread by another mosquito